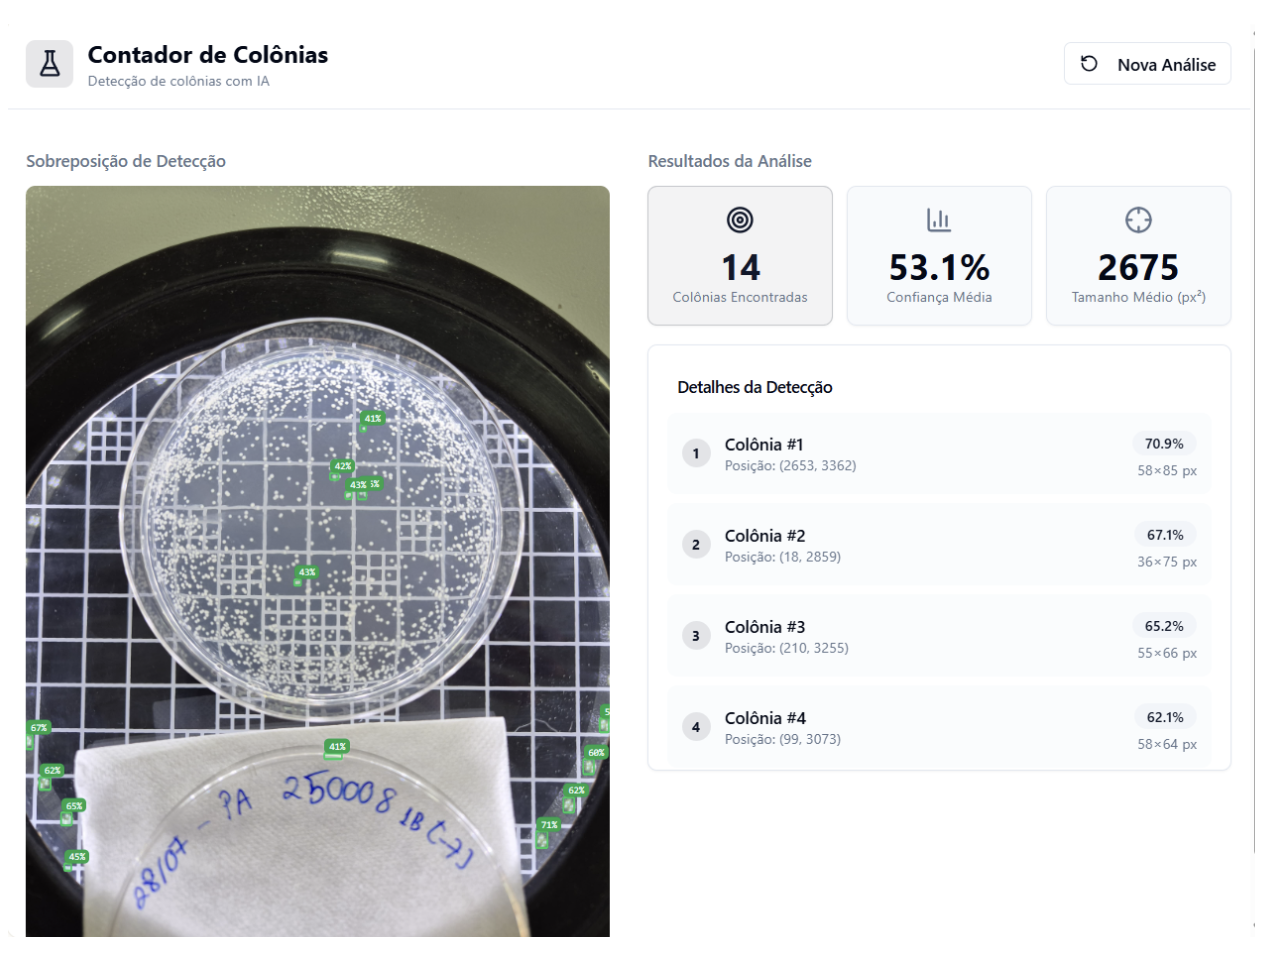

Every laboratory and industrial QC environment shares a common bottleneck: manual counting. Whether it’s cells, particles, or conidia, the traditional method involves a skilled professional spending hours staring through a microscope, clicking a manual counter, and battling eye fatigue.
The problem isn't just the time: it's the variability. Two technicians might look at the same sample and come up with two different numbers. In a regulated industry, that inconsistency is an operational risk.
By moving from manual tallies to an automated computer vision pipeline, organizations are able to achieve a standardized, digital process. I'm Rodrigo Silva, CIO at Nitro, and our implementation of this workflow using Roboflow Rapid for conidia counting recently saved over 600 hours per month.
That isn't just a cost reduction. It’s a massive unlock for our team to focus on innovation instead of repetitive labor.

Here I'll share how we built our solution, and the steps to take to build your own.
How Our Conidia Counting Solution Works
Here is how we’ve structured the end-to-end conidia counting workflow to ensure every plate is analyzed with total precision and traceability.
1. Data Acquisition
The process begins with the receipt of plates containing the colonies. Each sample is carefully handled to ensure integrity and proper identification, maintaining consistency from the very first step. This stage is critical, as it sets the foundation for accurate analysis and reliable results throughout the entire workflow.
Once the samples are received, the plates are placed under a microscope, where high-resolution images are captured. This step is essential to ensure that the visual data used by the system is clear, detailed, and suitable for precise analysis. The quality of these images directly influences the performance of the artificial intelligence model, making this a key part of the process.
2. Seamless Ingestion via Roboflow and Lovable
After capturing the images, they are uploaded into our artificial intelligence solution, developed using Lovable and powered by Roboflow. This integrated environment allows us to process the images efficiently, leveraging trained computer vision models specifically designed to identify and count conidia with high accuracy. The automation at this stage significantly reduces the need for manual intervention and accelerates the overall workflow.
3. Model Inference
The AI model analyzes each image and returns the quantified results, indicating the number of conidia detected in each sample. This output is generated quickly and consistently, ensuring that every analysis follows the same criteria and eliminates subjective interpretation. The reliability of these results is one of the main advantages of applying artificial intelligence in this context.
4. Data-Driven Quality Gates
Based on the quantified data and aligned with our established methodology, a decision is then made regarding the approval or rejection of the product. This step ensures that all samples meet predefined quality standards before moving forward. By combining automated analysis with structured evaluation criteria, the process becomes more robust and dependable.
5. The Operational Loop for Accuracy
This end-to-end workflow not only increases efficiency but also elevates the level of quality delivered to our clients. By minimizing human error, standardizing analysis, and ensuring consistent decision-making, we are able to provide more reliable products and greater confidence in our results.
Ultimately, this approach reinforces our commitment to excellence. By integrating computer vision and artificial intelligence into our operations, we are not only optimizing internal processes but also delivering higher quality outcomes that directly benefit our customers.
Conidia Counting Tutorial with Roboflow
This step-by-step guide walks you through our labeling process, automated training, and our final deployment of a custom interface designed for real-world laboratory throughput.
1. Setup your project
Start by creating a new project in your Roboflow dashboard. To automate counting, select Object Detection as your project type. Define your project settings, including a clear naming convention and visibility, to establish the digital foundation for your microscopy dataset.

2. Upload High-Quality Imagery
Populate your dataset by uploading high-quality microscope imagery directly into the Roboflow platform. For automated counting, your model is only as good as the pixels it sees. Ensure your uploads represent the real-world conditions of your lab, including variations in lighting, magnification, and conidia density.

Once your imagery is uploaded, organize your frames within Roboflow Rapid to kickstart the labeling process.

3. Annotate
Label each target object, identifying every individual conidia, to teach the model exactly what to prioritize and what to ignore as background noise. Once labeled, perform a high-level review to ensure absolute consistency across your dataset. Standardizing your labels now is the best defense against model drift and ensures the highest possible mAP once you choose to train.

4. Train and Deploy
Now, select "Review model" to let Roboflow’s managed infrastructure handle the heavy lifting. After training completes, deploy your model instantly as a hosted API endpoint or a local edge container to start counting conidia in production with a single line of code.


6. Evaluate the model
Test your model's performance by checking for precise bounding box alignment, analyze how the model handles overlapping conidia, and verify that your confidence scores represent actual prediction quality.

7. Improve the model
To improve your model's reliability, identify edge cases where the model struggled, feed those images back into your dataset, and refine your labels.

8. Create a Custom UI
Then, we used the Roboflow Inference API to build a lightweight interface - a custom app in Lovable. Users can easily upload a slide and get a pass/fail verdict in seconds without touching a line of code or leaving their familiar workflow.

With Roboflow providing the vision backbone and Lovable handling the user experience, we went from raw slides to a production-ready counting tool in a fraction of the time it takes to perform a single week of manual inspections.
Ready to digitize your QC workflow? Start building your counting model on Roboflow for free today.
Written by Rodrigo Silva
Cite this Post
Use the following entry to cite this post in your research:
Contributing Writer. (Mar 23, 2026). Revolutionizing Conidia Counting with Roboflow. Roboflow Blog: https://blog.roboflow.com/automating-conidia-counting/